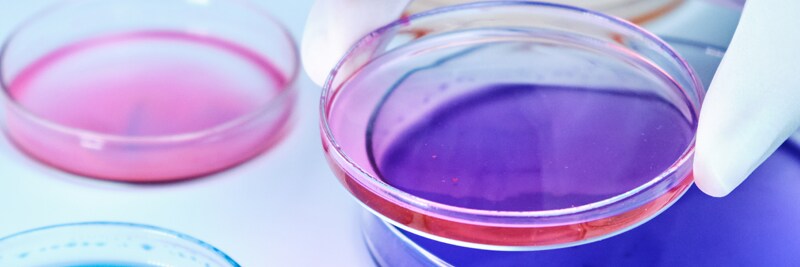
Cell Culture

BioAdvantage Program Benefits

We’re proud to be your prime vendor for laboratory supplies, providing products and value-added services focused on your current and future needs.
Customer Service
If you do not have a Fisher Scientific account or have difficulty signing in to your business account, please contact customer service.
Phone: 1-800-234-7437
Fax: 1-800-463-2996
As part of the BioAdvantage program, you’ll get the speed, service, and savings your work demands.
- Quickly enroll and get the supplies you need when you need them
- Access dedicated, specialized support groups
- Work with your Fisher Scientific sales representative to identify opportunities for savings and process improvements
Your Benefits
Here are some of the many rewards you’ll enjoy by choosing the Fisher Scientific channel as your primary supplier of laboratory and safety products:
- Special pricing on frequently purchased products
- Comprehensive discount schedule
- Annual tiered rebate incentives
- Savings on parts and services through Unity™ Lab Services
- Financing options
- And much more
En tant que leader en matière de pratiques de développement durable, Thermo Fisher Scientific est fier d’avoir reçu le statut Or d’EcoVadis, se classant ainsi parmi les 5 % des meilleures entreprises évaluées.

By submitting your data, you agree to our Privacy Policy and will receive emails based on your preferences.
© Thermo Fisher Scientific, Inc. All Rights Reserved.